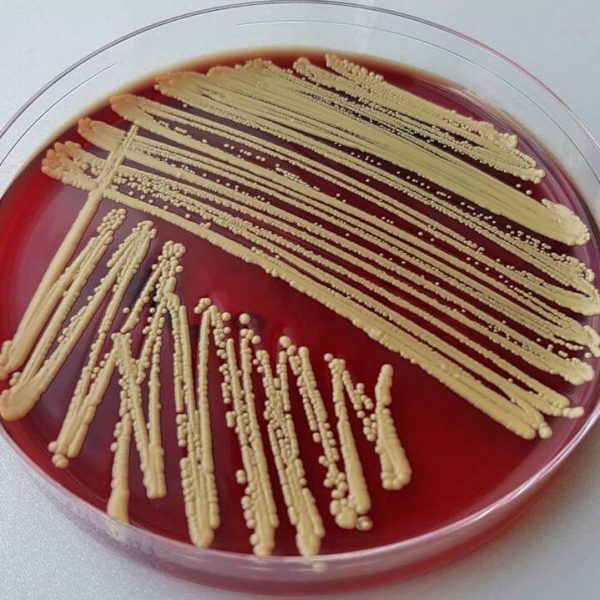
میکروکوکوس لوتوس (Micrococcus luteus) 1 میکروکوکوس لوتوس (Micrococcus luteus)
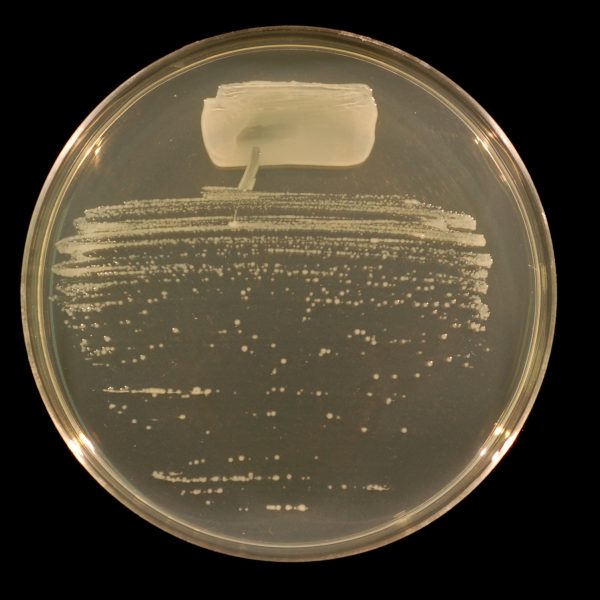
توکسین بایندر | خوراک دام | خوراک طیور |

کوکسی های گرم مثبت هستند که قطر آن ها 5~3.5 میکرون است. آرایش آن ها در زیر میکروسکوپ به اشکال دوتایی، چهارتایی، هشت تایی و یا خوشه ای دیده می شوند. کلنی های آن ها روی محیط کشت هایی از قبیل نوترینت آگار به اندازه 4 الی 6 میلی متر، گرد با سطح یکنواخت کناره ی صاف سطح کمی محدب، قوام کره ای کدر با پیگمان های رنگی سفید، زرد لیمویی، نارنجی و بدون بو می باشد. همگی آن ها دارای آنزیم کاتالاز بوده ولی بعضی از آن ها دارای آنزیم اکسیداز می باشند. هوازی مطلق و بعضی هوازی اختیاری هستند. یکی از میکروکوکوس ها، میکروکوکوس لوتئوس می باشد. کوکسی گرم مثبت، که قطر آن ها بین 1 الی 2 میکرون است. اگر روی نوترینت آگار کشت داده شوند قادر به ترشح پیگمان زرد یا طلایی یا نارنجی و یا زرد مایل به سبز می باشند. می توانند تا درجه حرارت 45 درجه سانتی گراد را نیز تحمل کنند. بنابراین این فاکتور آن را از سایر باکتری های این خانواده می تواند جدا سازد. در مجاورت نمک 7.5 درصد قادر به رشد نیستند ولی در محیط حاوی نمک 5 درصد رشد می کنند. احیا نیترات در آن ها منفی است. برخی از آن ها دارای آنزیم اوره آز هستند(اوره را به آمونیاک تبدیل می کنند). آنزیم اکسیداز و ژلاتیناز در آنها مثبت است. تخمیر قند گلوکز در آن ها منفی است. نمی توانند سیترات را به عنوان منبع کربن تجزیه کنند.
Micrococcus luteus ATCC4698

دیدگاهها
هیچ دیدگاهی برای این محصول نوشته نشده است.